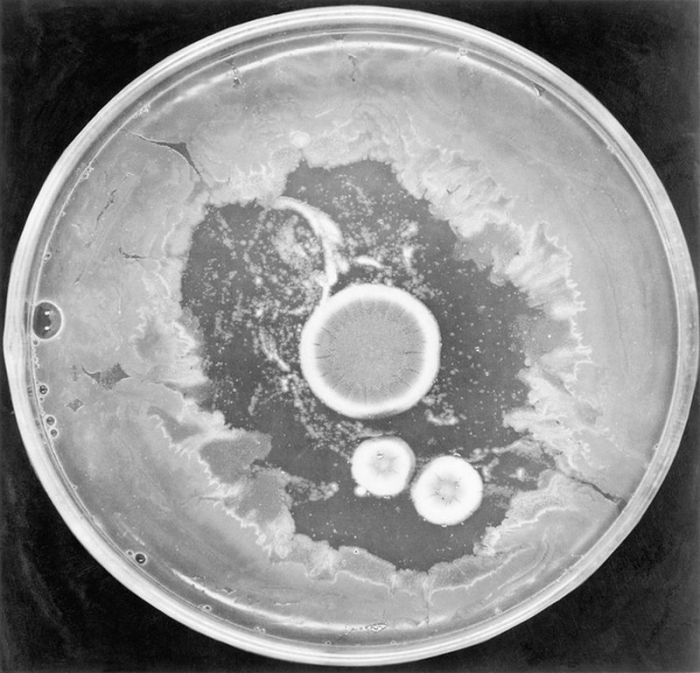

Кто из нас не принимал антибиотики? Препараты в звенящих ампулах или блестящих блистерах стали неотъемлемой частью современной медицины. Но до их появления люди умирали от воспаления легких, туберкулеза, а порой и от простой царапины, которая могла привести к заражению крови.
Распространение антибиотиков началось с пенициллина, а открыл чудодейственное средство — случайно — шотландец Александр Флеминг.
Выстрел судьбы
Александр Флеминг, сын шотландского фермера, вовсе не мечтал стать микробиологом. Он переехал в Лондон в четырнадцать лет, жил у своего старшего брата Тома, офтальмолога, и учился в Королевском политехническом институте, где изучал бизнес и коммерцию. Окончив вуз в 16 лет, будущий великий ученый устроился в судоходную компанию, где за четыре года работы понял, что не хочет этим заниматься.
О медицинской карьере Флеминг задумался в 20 лет, решив последовать примеру успешного брата. Он как раз получил наследство от дяди и потратил эти средства на обучение в медицинской школе больницы Святой Марии в лондонском районе Паддингтон, куда поступил в 1903 году в возрасте 22 лет. На тот момент в Лондоне было двенадцать учебных заведений, в которых Флеминг мог бы изучать медицину, но с муками выбора он разобрался радикально: вспомнил, что когда-то играл в составе ватерполистской команды против студентов училища при больнице Святой Марии, и решил поступать туда. Через три года он получил степень бакалавра медицины и сдал экзамены на хирурга.
Так к 1906 году Александр Флеминг имел все шансы посвятить свою жизнь хирургии, только для этого ему пришлось бы покинуть родную больницу Святой Марии, а у судьбы на молодого человека были совсем другие планы.
Все решилось по воле случая. Дело в том, что молодой медик во время учебы был по совместительству еще и членом стрелкового клуба, и глава этого клуба, доктор Джон Фримен, очень уж не хотел терять талантливого стрелка. Тогда Фримен предложил Флемингу работу в той же исследовательской группе больницы Святой Марии, в которой работал сам. Так Флеминг попал в ученики к Алмроту Райту — британскому иммунологу и бактериологу, создателю вакцины от брюшного тифа.
Под руководством Райта Флеминг увлекся бактериологией и в 1908 году получил степень бакалавра в этой сфере — с золотой медалью как лучший студент.
С началом Первой мировой Флеминг присоединился к медицинскому корпусу Королевской армии и провел ряд экспериментов, которые доказали: использующиеся для обработки ран антисептики приносят больше вреда, чем пользы, так как не могут уничтожить бактерии в глубоких ранах и снижают фактическую сопротивляемость организма инфекциям, убивая лейкоциты. Это стало первым из серьезных открытий ученого.
Следующее произойдет в 1922 году. К этому времени Флеминг уже вернулся с фронта в родную лабораторию при больнице Святой Марии. Он посвятил свои труды поиску антибактериальных препаратов, насмотревшись на шокирующие случаи смерти солдат от гангрены и сепсиса на фронте.
Талантливый ученый, Флеминг не отличался аккуратностью в своих изысканиях, но неряшливость ему только помогала. Так, как-то явившись на работу простуженным, он чихнул в чашку Петри, где выращивал бактерии, и открыл лизоцим, природный антисептик, способный разрушать клеточные стенки некоторых бактерий. Лизоцим, конечно, не был панацеей и не справлялся с серьезными заболеваниями, но это было только начало.
Забытая чашка Петри
Неряшливость Флеминга изменила медицину спустя шесть лет после открытия лизоцима — только люди не сразу это осознали. Как же это произошло?
Шел 1928 год. Александр Флеминг вернулся в лабораторию после длительного отпуска с семьей и обнаружил на столе забытые чашки Петри с культурой стафилококка. Он провел ревизию и выяснил, что в некоторые из чашек попали плесневые грибы — и вокруг них совсем не было бактерий! Это насторожило ученого. Он пришел к выводу, что плесень содержит антибактериальное вещество, убивающее стафилококк, и посвятил следующие дни определению вида грибка, попавшего в чашки.
Грибок Penicillium notatum действительно обладает антибиотическим свойством, и ученый назвал действующее вещество пенициллином. В ходе исследований Флеминг выяснил: средство эффективно против стафилококка, а также возбудителей скарлатины, пневмонии, гонореи, менингита и дифтерии.
Флеминг представил свое открытие научному сообществу в 1929 году: его статья о пенициллине была опубликована в Британском журнале экспериментальной патологии, но не вызвала бурной реакции у коллег. Спустя семь лет он выступил с докладом на Втором международном конгрессе микробиологов в Лондоне, где продемонстрировал изначальный опыт с Penicillium notatum и стафилококком, однако снова никто не поддержал мнение ученого о потенциальной пользе обнаруженного вещества для лечения инфекций у людей.
Уверенный в своей правоте, Флеминг не оставил исследования, но извлечение из плесени действующего вещества, его подготовка для длительного хранения и производство препарата в промышленных масштабах оказались настоящим вызовом, справиться с которым ученому в тот момент было не по силам. Все изменилось совсем скоро.
Плесень животворящая
Не то чтобы до Флеминга никто и не думал о противовоспалительных свойствах плесени. Заплесневелые продукты использовались для лечения ран в Древнем Китае, Древнем Египте и Империи инков, описания применения грибков в лечебных целях встречаются в работах Парацельса и Авиценны.
Ученые XIX и XX веков также проводили исследования в этом направлении. Так, француз Эрнест Дюшен выступал в институте Пастера в Париже с докладом о разрушительном действии плесени на возбудитель брюшного тифа, а американцы Карл Альсберг и Отис Фишер Блэк за год до начала Первой мировой войны смогли выделить из грибка кислоту с противомикробным действием. Но эти работы не получили признания.
Пенициллин и Вторая мировая война
Своим будущим пенициллин обязан не только Александру Флемингу, но и микробиологу Эрнсту Чейну, который переехал в Великобританию из Германии в 1933 году из-за прихода к власти на родине нацистов. Чейн получил работу в Оксфордском университете под началом профессора Говарда Флори, где занялся исследованием антибактериальных веществ. В частности, Чейна заинтересовала одна из публикаций Флеминга про пенициллин, и они вместе с Флори сосредоточились на этом направлении. 
В 1939-м Чейн наконец смог получить из плесени порошкообразный препарат для последующих исследований. Ученые решились на контрольный опыт на мышах: грызунов заразили смертельными бактериями, и те из животных, что получали пенициллин, смогли выжить. Оставалось главное: доказать эффективность лекарства для людей.
Первая внутривенная инъекция пенициллина была сделана 12 февраля 1941 года лондонскому полицейскому, страдавшему от заражения крови. Результаты впечатлили: пациент пошел на поправку и прожил еще месяц, а скончался лишь потому, что выделенного пенициллина не хватило для полной победы над недугом. Перед учеными возникла новая проблема: организовать массовое производство препарата в Великобритании, которая подвергалась постоянным бомбардировкам со стороны фашистской Германии, оказалось невозможно.
Осознав всю сложность ситуации, британцы обратились за помощью к американским коллегам, и в США удалось начать производство первого антибиотика. Тогда потребность в нем уже была очевидна: в разгар Второй мировой пенициллин мог спасти жизни солдат, умиравших на поле боя не столько от вражеского огня, сколько от попадавших в раны инфекций.
Заинтересовались открытием Флеминга и в Советском Союзе. Не получив из Великобритании запрошенный еще в начале войны штамм плесени, в СССР начали разработку собственного пенициллина. Занималась этим специально созданная лаборатория экспериментальной медицины под руководством профессора Зинаиды Ермольевой. Первый советский пенициллин был выделен из грибка Penicillium crustosum.
В 1943 году наладить производство антибиотика наконец получилось и в Британии, препарат начали поставлять в армию, были проведены успешные испытания средства для лечения раненых — пенициллин получил долгожданное признание. Ученые бросили все свои усилия на исследования и производство антибиотика: они искали новые штаммы плесени, способные выделять больше действующего вещества. Так был обнаружен Penicillium chrysogenum, из него смогли получить в 400 раз больше пенициллина, чем из использованного Флемингом Penicillium notatum.
Советский же пенициллин прошел «боевое крещение» в 1944-м — именно тогда он поступил в военные госпитали и начал применяться для лечения тяжелораненых солдат.
За период использования во время Второй мировой войны пенициллин свел к нулю смертность от гангрены в союзной армии, что стало значительным преимуществом, ведь потери противника, лишенного доступа к антибиотику, оставались на прежнем уровне. После завершения войны в 1945 году Флеминг, Чейн и Флори были удостоены за свои исследования и открытия Нобелевской премии.
Памятник Зинаиде Ермольевой в Ростове-на-Дону
А что сейчас
В 2028 году пенициллин отметит свой сотый день рождения. За это время было открыто несколько тысяч новых антибиотиков, объединенных в шестнадцать больших классов. Да и сам пенициллин, как и родственные ему препараты, до сих пор используется, только сегодня он подходит для лечения намного более узкого спектра болезней, чем в свои «золотые» годы. Почему? Человечество столкнулось с новой проблемой, и имя ей — антибиотикорезистентные бактерии.
Со временем микроорганизмы мутируют, приспосабливаясь к действию препаратов, — обретают резистентность. О таком развитии событий предупреждал Александр Флеминг: он утверждал, что пациентам нельзя вводить пенициллин в небольших дозах в течение непродолжительного времени. Иными словами, курс лечения должен быть полным, и это касается не только пенициллина.
Дело в том, что в организме пациента, принимающего антибиотики неправильно, погибают не все болезнетворные микроорганизмы — часть из них выживает, приобретает устойчивость и заражает новых носителей. Так, например, некоторые бактерии «научились» вырабатывать пенициллиназу — специальный фермент, расщепляющий пенициллин и некоторые другие антибиотики.
Пусть мы об этом и не задумываемся, но проблема резистентности бактерий становится все более острой: ученые отмечают, что в последнее время микроорганизмы приспосабливаются к антибиотикам быстрее, чем человечество успевает найти новые способы борьбы с ними.
Нельзя утверждать, что в поиске новых антибиотиков наука стоит на месте: так, в январе 2015 года было объявлено об открытии нового средства — теиксобактина, отличающегося эффективностью против бактерий, уже выработавших устойчивость к другим антимикробным препаратам. Но до начала его широкого использования пройдут годы, ведь после открытия лекарства нужно провести все необходимые исследования. Кроме того, теиксобактин стал первым новым антибиотиком за долгие годы, а сколько бактерий за это время успело развить резистентность, неизвестно. Человечество просто не успевает за скоростью мутации микроорганизмов, к тому же мы ухудшаем ситуацию сами, бесконтрольно принимая антибиотики.
Итак, почти век назад пенициллин стал «волшебной палочкой», превратившей смертельные болезни в излечимые, но справится ли человечество с антибиотикорезистентными бактериями? Быть может, нам нужен еще один ученый-неряха, который забудет на лабораторном столе грязную чашку Петри?






